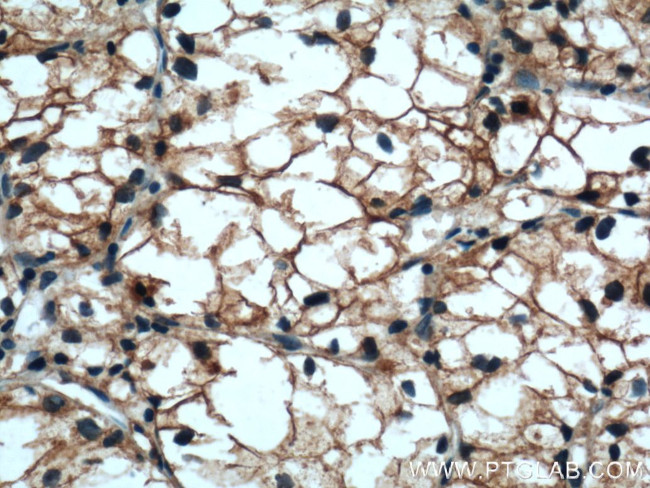
Cadherin-16 Antibody in Immunohistochemistry (Paraffin) (IHC (P))

Search
Proteintech
Cadherin-16 Polyclonal Antibody
{{$productOrderCtrl.translations['antibody.pdp.commerceCard.promotion.promotions']}}
{{$productOrderCtrl.translations['antibody.pdp.commerceCard.promotion.viewpromo']}}
{{$productOrderCtrl.translations['antibody.pdp.commerceCard.promotion.promocode']}}: {{promo.promoCode}} {{promo.promoTitle}} {{promo.promoDescription}}. {{$productOrderCtrl.translations['antibody.pdp.commerceCard.promotion.learnmore']}}
产品信息
15107-1-AP
种属反应
已发表种属
宿主/亚型
分类
类型
抗原
偶联物
形式
浓度
规格
纯化类型
保存液
内含物
保存条件
运输条件
产品详细信息
Immunogen sequence: AQPAELSVE VPENYGGNFP LYLTKLPLPR EGAEGQIVLS GDSGKATEGP FAMDPDSGFL LVTRALDREE QAEYQLQVTL EMQDGHVLWG PQPVLVHVKD ENDQVPHFSQ AIYRARLSRG TRPGIPFLFL EASDRDEPGT ANSDLRFHIL SQAPAQPSPD MFQLEPRLGA LALSPKGSTS LDHALERTYQ LLVQVKDMGD QASGHQATAT VEVSIIESTW VSLEPIHLAE NLKVLYPHHM AQVHWSGGDV HYHLESHPPG PFEVNAEGNL YVTRELDREA QAEYLLQVRA QNSHGEDYAA PLELHVLVMD ENDNVPICPP RDPTVSIPEL SP (20-350 aa encoded by BC027912)
靶标信息
The cadherins are a family of Ca2+-dependent adhesion molecules that function to mediate cell-cell binding critical to the maintenance of structure and morphogenesis. Cadherins each contain a large extracellular domain at the N-terminus, which is characterized by a series of five homologous repeats, the most distal of which is thought to be responsible for binding specificity. Cadherin-16, also known as Ksp-Cadherin, is a type I membrane protein which is kidney-specific. Cadherin-16 is expressed exclusively in the basolateral membrane of renal tubular epithelial cells. The human Ksp-cadherin gene (Cadherin-16) maps to chromosome 16q21-proximal 16q22. The mouse Ksp-cadherin gene was localized to a highly syntenic region of distal Chromosome 8.
仅用于科研。不用于诊断过程。未经明确授权不得转售。
生物信息学
蛋白别名: Cadherin; cadherin 16, KSP-cadherin; Cadherin-16; Cadherin-16 (CDH16); CDH 16; Kidney-specific cadherin; KSP-cadherin; Ksp-cadherin antibody; unnamed protein product
基因别名: CDH16; UNQ695/PRO1340
UniProt ID: (Human) O75309, (Mouse) O88338
Entrez Gene ID: (Human) 1014, (Rat) 307614, (Mouse) 12556